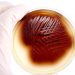
Asymptomatic Bacterial Urinary Tract Infection

Bacteriuria is the presence of microorganisms in the urine. It can be the symptom of a urinary tract infection, urethritis, or cystitis. If you have these symptoms, you may need antibiotics.
The incidence of bacteriuria varies depending on the patient’s age and the health of the urinary tract. Usually, the bacterial population in urine is very low. When the number of bacteria in the urine increases, it means that the urinary system is inflamed. In cases of severe inflammation, antibiotics are administered. Antibiotics are used to treat a variety of infectious diseases. They are safe when taken in adequate dosage and when they meet bioavailability criteria. However, they should be prescribed only by a physician.
Although most cases of bacteriuria are treated, some are left untreated. Some individuals have no symptoms of infection, yet they still suffer from a recurrent urinary tract infection. These people need to be examined regularly. Other patients have symptoms such as a burning sensation when they urinate, painful urination, and a persistent urge to urinate. Several different infectious agents are responsible for these illnesses. One of the most common is Escherichia coli. Another pathogen is Enterococcus species. Others include brucellosis and leptospirosis. There are many other causes of bacteriuria, and it is possible for these infections to occur with or without symptoms.
Women are the most susceptible to asymptomatic bacteriuria. Women who have a urinalysis that shows a high count of microbial bodies have an increased risk for pyelonephritis. Because of this, women with asymptomatic bacteriuria should be tested regularly.
Pregnant women should also be screened for asymptomatic bacteriuria. If the urine culture shows a high count of microbial body, the pregnant woman should be treated with antibiotics for a period of three to seven days. This will lower her chances of developing a pyelonephritis, which is dangerous for both the mother and the baby. For women who have a UTI, it is best to return to the doctor if the symptoms of infection recur.
Children can also have bacteriuria, but it is often not a serious problem. Treating the child will usually require only a few urinations and proper adherence to hygiene rules. Regular baths are effective in treating bacteriuria. Often, children can get over their infections by urinating regularly and by eliminating the main source of the infection.
As mentioned, asymptomatic bacteriuria can occur in both men and women, and it is usually found in patients who have abnormalities in the urinary tract. Symptoms of asymptomatic bacteriuria are not usually associated with inflammation or pain. Instead, asymptomatic bacteriuria is most often associated with a variety of urinary tract abnormalities, including a prostate hyperplasia or an overgrown ureter. Among women with asymptomatic bacteriuria, the risk of pyelonephritis is up to 40 percent.
Patients who have asymptomatic bacteriuria during pregnancy are at a higher risk for placental insufficiency and a low birth-weight baby. Therefore, the treatment for asymptomatic bacteriuria in these cases should include a repeat urine culture every three to six weeks until delivery.